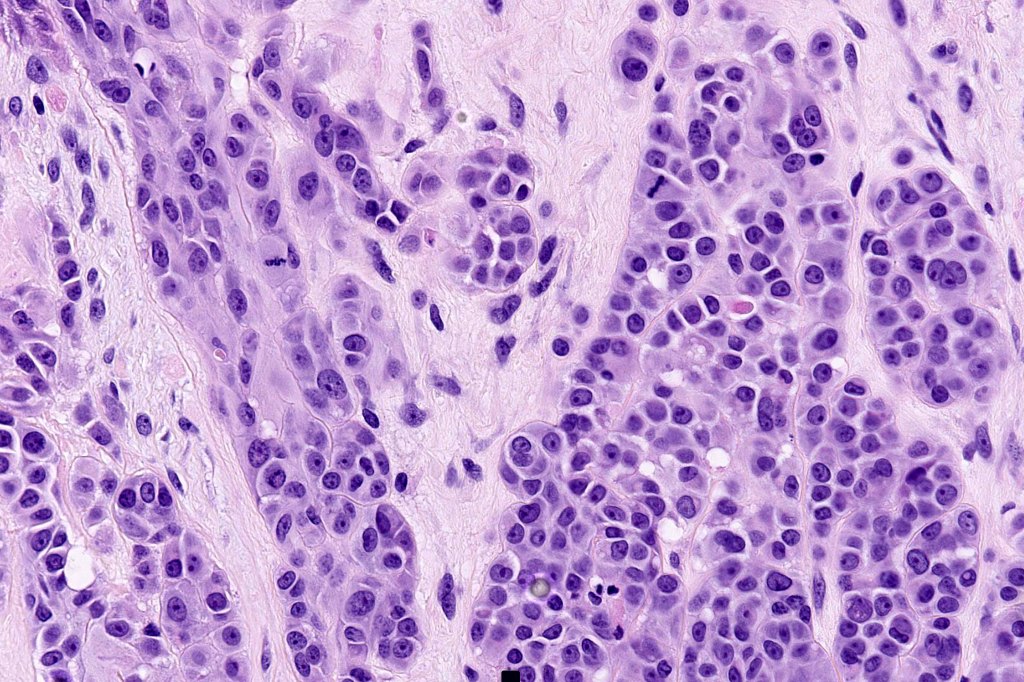

A variant of nodular melanoma which shows some/many of the features typically seen in Spitz nevus
It can be divided into 3 categories
- Spitz melanoma in which genetic alterations seen in Spitz nevus including HRAS mutation or fusion involving BRAF, ALK, NTRK1 or MAP3K8 can be identified
- Spitzoid melanoma without a MAPK activating mutation
- Spitzoid melanoma with a MAPK activating mutation involving non-V600 residues of BRAF & NRAS, MAP2K1/2, NF1 & KIT

Clinical features
While any age may be affected, the majority occur in the 2nd decade with a predilection for females
Exceptionally, cases are encountered in children
Prognosis depends upon the subtype (see abstract)
Histological features

•>5-10 mm
•Involve deep dermis or subcutis
•Asymmetrical, poorly circumscribed
•May show effacement/consumption of epidermis or ulceration
•Peripheral Pagetoid spread
•Large nodules which often show impaired maturation
•Loss of gradient with HMB45 and Ki67
•>20% Ki67 expression
•TERT promoter & PTEN mutations
•DNA copy-number variations

Differential diagnosis
Spitz nevus & atypical Spitz nevus/tumor will be discussed in a separate blog
Leave a comment